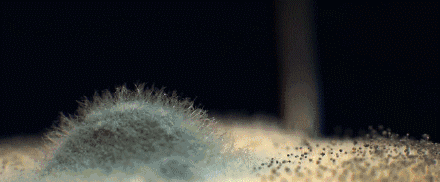
图片

加上上班久坐,令人困扰的除了小肚子,还有臀部扁塌、下垂、假胯宽。跟女星们蜜桃臀,小蛮腰的好身材一比,自己简直就是中年大妈!靠运动减肥是真的指望不上了,只能寻找“作弊神器”了!特别是那种一整排扣的,巨紧!巨难穿!勒到喘不过气来!心肺、子宫、肠胃长时间受压,容易造成不可逆转的伤害。满是分泌物和体汗闷着的内裤,更是个大型细菌培育皿。世界卫生组织不止多次警告:女性80%的妇科病与内裤有关❗
就是这款雪梵莱X黑绷带桑蚕丝收腹裤。

原价69元/条,现在暖冬福利价150积分+79元/6条!把内裤换成它,就能轻松拥有蜜桃臀+小蛮腰 就连塌PP,在它的3D提臀设计下,都瞬间变得圆润挺翘。亲肤抑jun,吸湿透气,24小时贴身呵护“秘密花园”!X黑绷带桑蚕丝收腹裤,一条解决万千烦恼,真的超惊艳!因为它不仅仅是高腰版型设计。腰部还增加创新“黑绷带黄金科学定点分压”塑身技术。X型环绕式加压,让游离赘肉集中,收腹效果吊打普通高腰内裤。
就连塌PP,在它的3D提臀设计下,都瞬间变得圆润挺翘。亲肤抑jun,吸湿透气,24小时贴身呵护“秘密花园”!X黑绷带桑蚕丝收腹裤,一条解决万千烦恼,真的超惊艳!因为它不仅仅是高腰版型设计。腰部还增加创新“黑绷带黄金科学定点分压”塑身技术。X型环绕式加压,让游离赘肉集中,收腹效果吊打普通高腰内裤。
为了达到“一穿即翘”的好效果,臀部位置特意比对完美翘臀的黄金比例。添加了性感3D立体桃心臀杯设计,穿上后秒变圆润又挺翘的蜜桃臀。视觉上秒瘦10斤不是梦~身材立马火辣迷人,妥妥的背影杀手!360°无缝包裹臀部,且自带弹性提拉带。不夹臀不卡裆。即使下蹲、走路都不会钻进缝缝里,再也不用偷偷摸摸揪内裤了。
采用无缝剪裁技术,整条收腹裤每一处都能紧密无缝贴合。所以,建议大家冬天还是选择吸湿透气、抑jun的内裤哦~桑蚕丝富含18种对人体有益的氨基酸,被称为“人体的第二层肌肤”。并且吸湿透气性远超普通棉!抗jun的效果是纯棉的1.5倍!将收腹内裤盖在蒸汽机上,热气一碰到它就逃窜出来了~每一处的走线都平整美观。能很大程度上减少摩擦,做到贴身仿若无物。温柔的莫兰迪色系狠狠拿捏住了偶滴少女心。 每个颜色都好好看啊!而且还都是独立包装~真滴干净又卫生!
每个颜色都好好看啊!而且还都是独立包装~真滴干净又卫生!150积分+79元/六条!一条一杯奶茶钱都不用。无脑冲!!入手几条自穿,送妈妈、闺蜜都超nice~
点击下方图片
一起得双旦好礼!